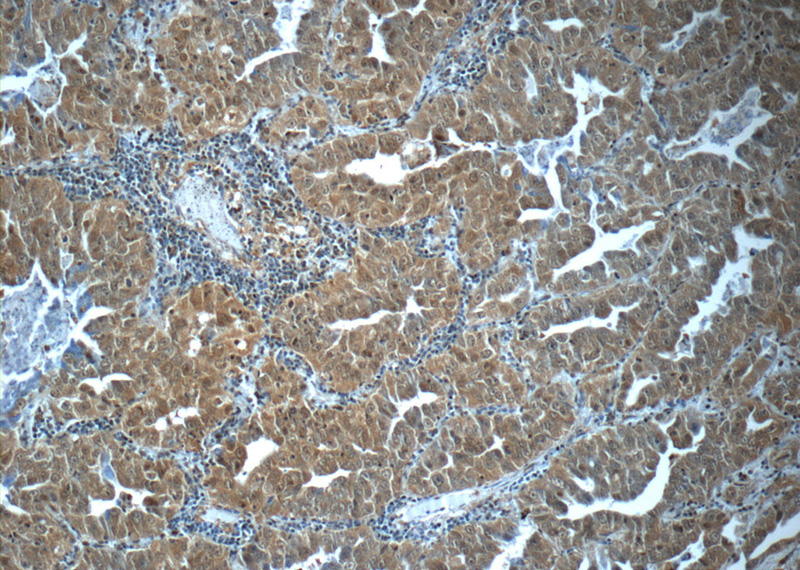
Immunohistochemistry of paraffin-embedded human lung cancer tissue slide using Catalog No:111099(GMFG Antibody) at dilution of 1:50 (under 10x lens)

-
Product Name
GMFG antibody
- Documents
-
Description
GMFG Rabbit Polyclonal antibody. Positive IHC detected in human lung cancer tissue, human heart tissue, human kidney tissue, human placenta tissue, human spleen tissue, human testis tissue. Positive WB detected in rat brain tissue, human heart tissue, human placenta tissue, mouse placenta tissue. Positive IP detected in mouse spleen tissue. Observed molecular weight by Western-blot: 17 kDa
-
Tested applications
ELISA, IHC, IP, WB
-
Species reactivity
Human, Mouse, Rat; other species not tested.
-
Alternative names
Glia maturation factor gamma antibody; glia maturation factor antibody; gamma antibody; GMF GAMMA antibody; GMFG antibody
-
Isotype
Rabbit IgG
-
Preparation
This antibody was obtained by immunization of GMFG recombinant protein (Accession Number: NM_004877). Purification method: Antigen affinity purified.
-
Clonality
Polyclonal
-
Formulation
PBS with 0.02% sodium azide and 50% glycerol pH 7.3.
-
Storage instructions
Store at -20℃. DO NOT ALIQUOT
-
Applications
Recommended Dilution:
WB: 1:200-1:2000
IP: 1:200-1:2000
IHC: 1:20-1:200
-
Validations

rat brain tissue were subjected to SDS PAGE followed by western blot with Catalog No:111099(GMFG Antibody) at dilution of 1:600

IP Result of anti-GMFG (IP:Catalog No:111099, 4ug; Detection:Catalog No:111099 1:500) with mouse spleen tissue lysate 4000ug.
Immunohistochemistry of paraffin-embedded human lung cancer tissue slide using Catalog No:111099(GMFG Antibody) at dilution of 1:50 (under 10x lens)

Immunohistochemistry of paraffin-embedded human lung cancer tissue slide using Catalog No:111099(GMFG Antibody) at dilution of 1:50 (under 40x lens)
-
Background
GMFG (glia maturation factor-γ), is a 17 kDa protein that belongs to the GMF subfamily of the larger Actin-binding protein ADF family. In adult rat, the GMFG mRNA is predominantly expressed in the thymus, testis, and lung. GMFG is considered a hematopoietic-specific protein that may mediate the pluripotentiality and lineage commitment of human hematopoietic stem cells. GMFG has several serine/threonine (Ser/Thr) phosphorylation sites, and can be phosphorylated at N-terminal serine, and its phosphorylation is enhanced by coexpression of dominant active Rac1 and Cdc42. Expression of GMFG enhances actin-based cellular functions such as migration and tube-formation in endothelial cells. GMFG expression is also significantly increased in a cardiac ischemia/reperfusion model where inflammation and angiogenesis take place actively.
-
References
- Lippert DN, Wilkins JA. Glia maturation factor gamma regulates the migration and adherence of human T lymphocytes. BMC immunology. 13:21. 2012.
- Nam J, Onitsuka I, Hatch J. Coronary veins determine the pattern of sympathetic innervation in the developing heart. Development (Cambridge, England). 140(7):1475-85. 2013.
Related Products / Services
Please note: All products are "FOR RESEARCH USE ONLY AND ARE NOT INTENDED FOR DIAGNOSTIC OR THERAPEUTIC USE"
